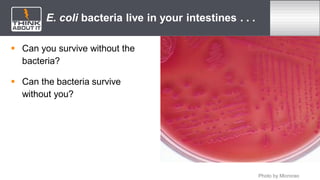
E. coli bacteria live in your intestines . . .
 Can you survive without the
bacteria?
 Can the bacteria survive
without you?
Photo by Microrao

This document provides definitions for key vocabulary terms related to relationships among organisms, including predation, competition, mutualism, commensalism, parasitism, interdependence, coevolution, introduced species, and invasive species. It also defines species and ecosystem as prerequisite vocabulary. The document aims to describe the major types of interactions between organisms and explain how symbiotic relationships and invasive species affect the environment.

![ You have a symbiotic relationship with the E. coli bacteria that live in
your intestines.
The bacteria gain nutrition and a place to live.
You gain essential nutrients.
Which type of symbiotic relationship does this describe?
[space for teacher to write]
E. Coli Bacteria](https://image.slidesharecdn.com/relationshipsamongorganismsppt1-221010075226-25b48945/85/Relationships-Among-Organisms-PPT-1-pptx-16-320.jpg)


















![*
Recall Invasive Species
How do introduced species become
established in a new ecosystem? Check all
that apply.
[ ] introduced to a habitat similar to their own
[ ] introduced to a habitat different than their
own
[ ] outcompete native species
[ ] generally have no native predators
[ ] generally have native predators
[ ] often have high reproductive rates
[ ] often have low reproductive rates
[ ] can tolerate a range of conditions
How are species introduced to new
ecosystems? Check all that apply.
[ ] carried in on cargo crates
[ ] traveled in or on ships
[ ] result from mutations in other organisms
[ ] hidden inside produce or meat
[ ] carried on clothing or in luggage
[ ] intentionally introduced by humans
[ ] coevolution of two species](https://image.slidesharecdn.com/relationshipsamongorganismsppt1-221010075226-25b48945/85/Relationships-Among-Organisms-PPT-1-pptx-35-320.jpg)








![*
Explore Predators
What are the three main weapons of
predators?
[text area 3 lines]
Check the items you included.
[-] claws
[-] jaws
[-] teeth
Read the information on predators using this
link, then answer the questions provided.
Which organisms are considered predators?
Check all that apply.
[ ] organisms that eat meat
[] organisms that eat plants
[ ] organisms that eat carcasses of animals
[] organisms that eat plants and animals](https://image.slidesharecdn.com/relationshipsamongorganismsppt1-221010075226-25b48945/85/Relationships-Among-Organisms-PPT-1-pptx-44-320.jpg)

![*
Explore Invasive Species
Check the items you included.
[-] Homeland Europe and Asia
[-] invaded the entire state of Wisconsin
[-] can burn your skin
[-] reproduces rapidly
[-] can be removed at root or with a power
brush cutter for large populations
Read about invasive species in Wisconsin
using this link, then answer the questions
provided.
Describe the invasion of wild parsnip including
the harm it is causing.
[text area 5 lines]](https://image.slidesharecdn.com/relationshipsamongorganismsppt1-221010075226-25b48945/85/Relationships-Among-Organisms-PPT-1-pptx-46-320.jpg)
![*
Explore Invasive Species
Check the items you included.
[-] brush or pick seeds off your clothes
[-] put seeds you find at home in the trash
[-] clean your pets (coat and feet) to remove
seeds and plant parts you find
[-] stay on trails when hiking
[-] check boats, trailers, shoes, bikes, and
people for plant seeds or plant parts
[-] use firewood in the same place you find it
to avoid transferring seeds
Read about defending invasive species using
this link, then answer the questions provided.
Describe how you can avoid spreading
invasive plant species.
[text area 6 lines]](https://image.slidesharecdn.com/relationshipsamongorganismsppt1-221010075226-25b48945/85/Relationships-Among-Organisms-PPT-1-pptx-47-320.jpg)